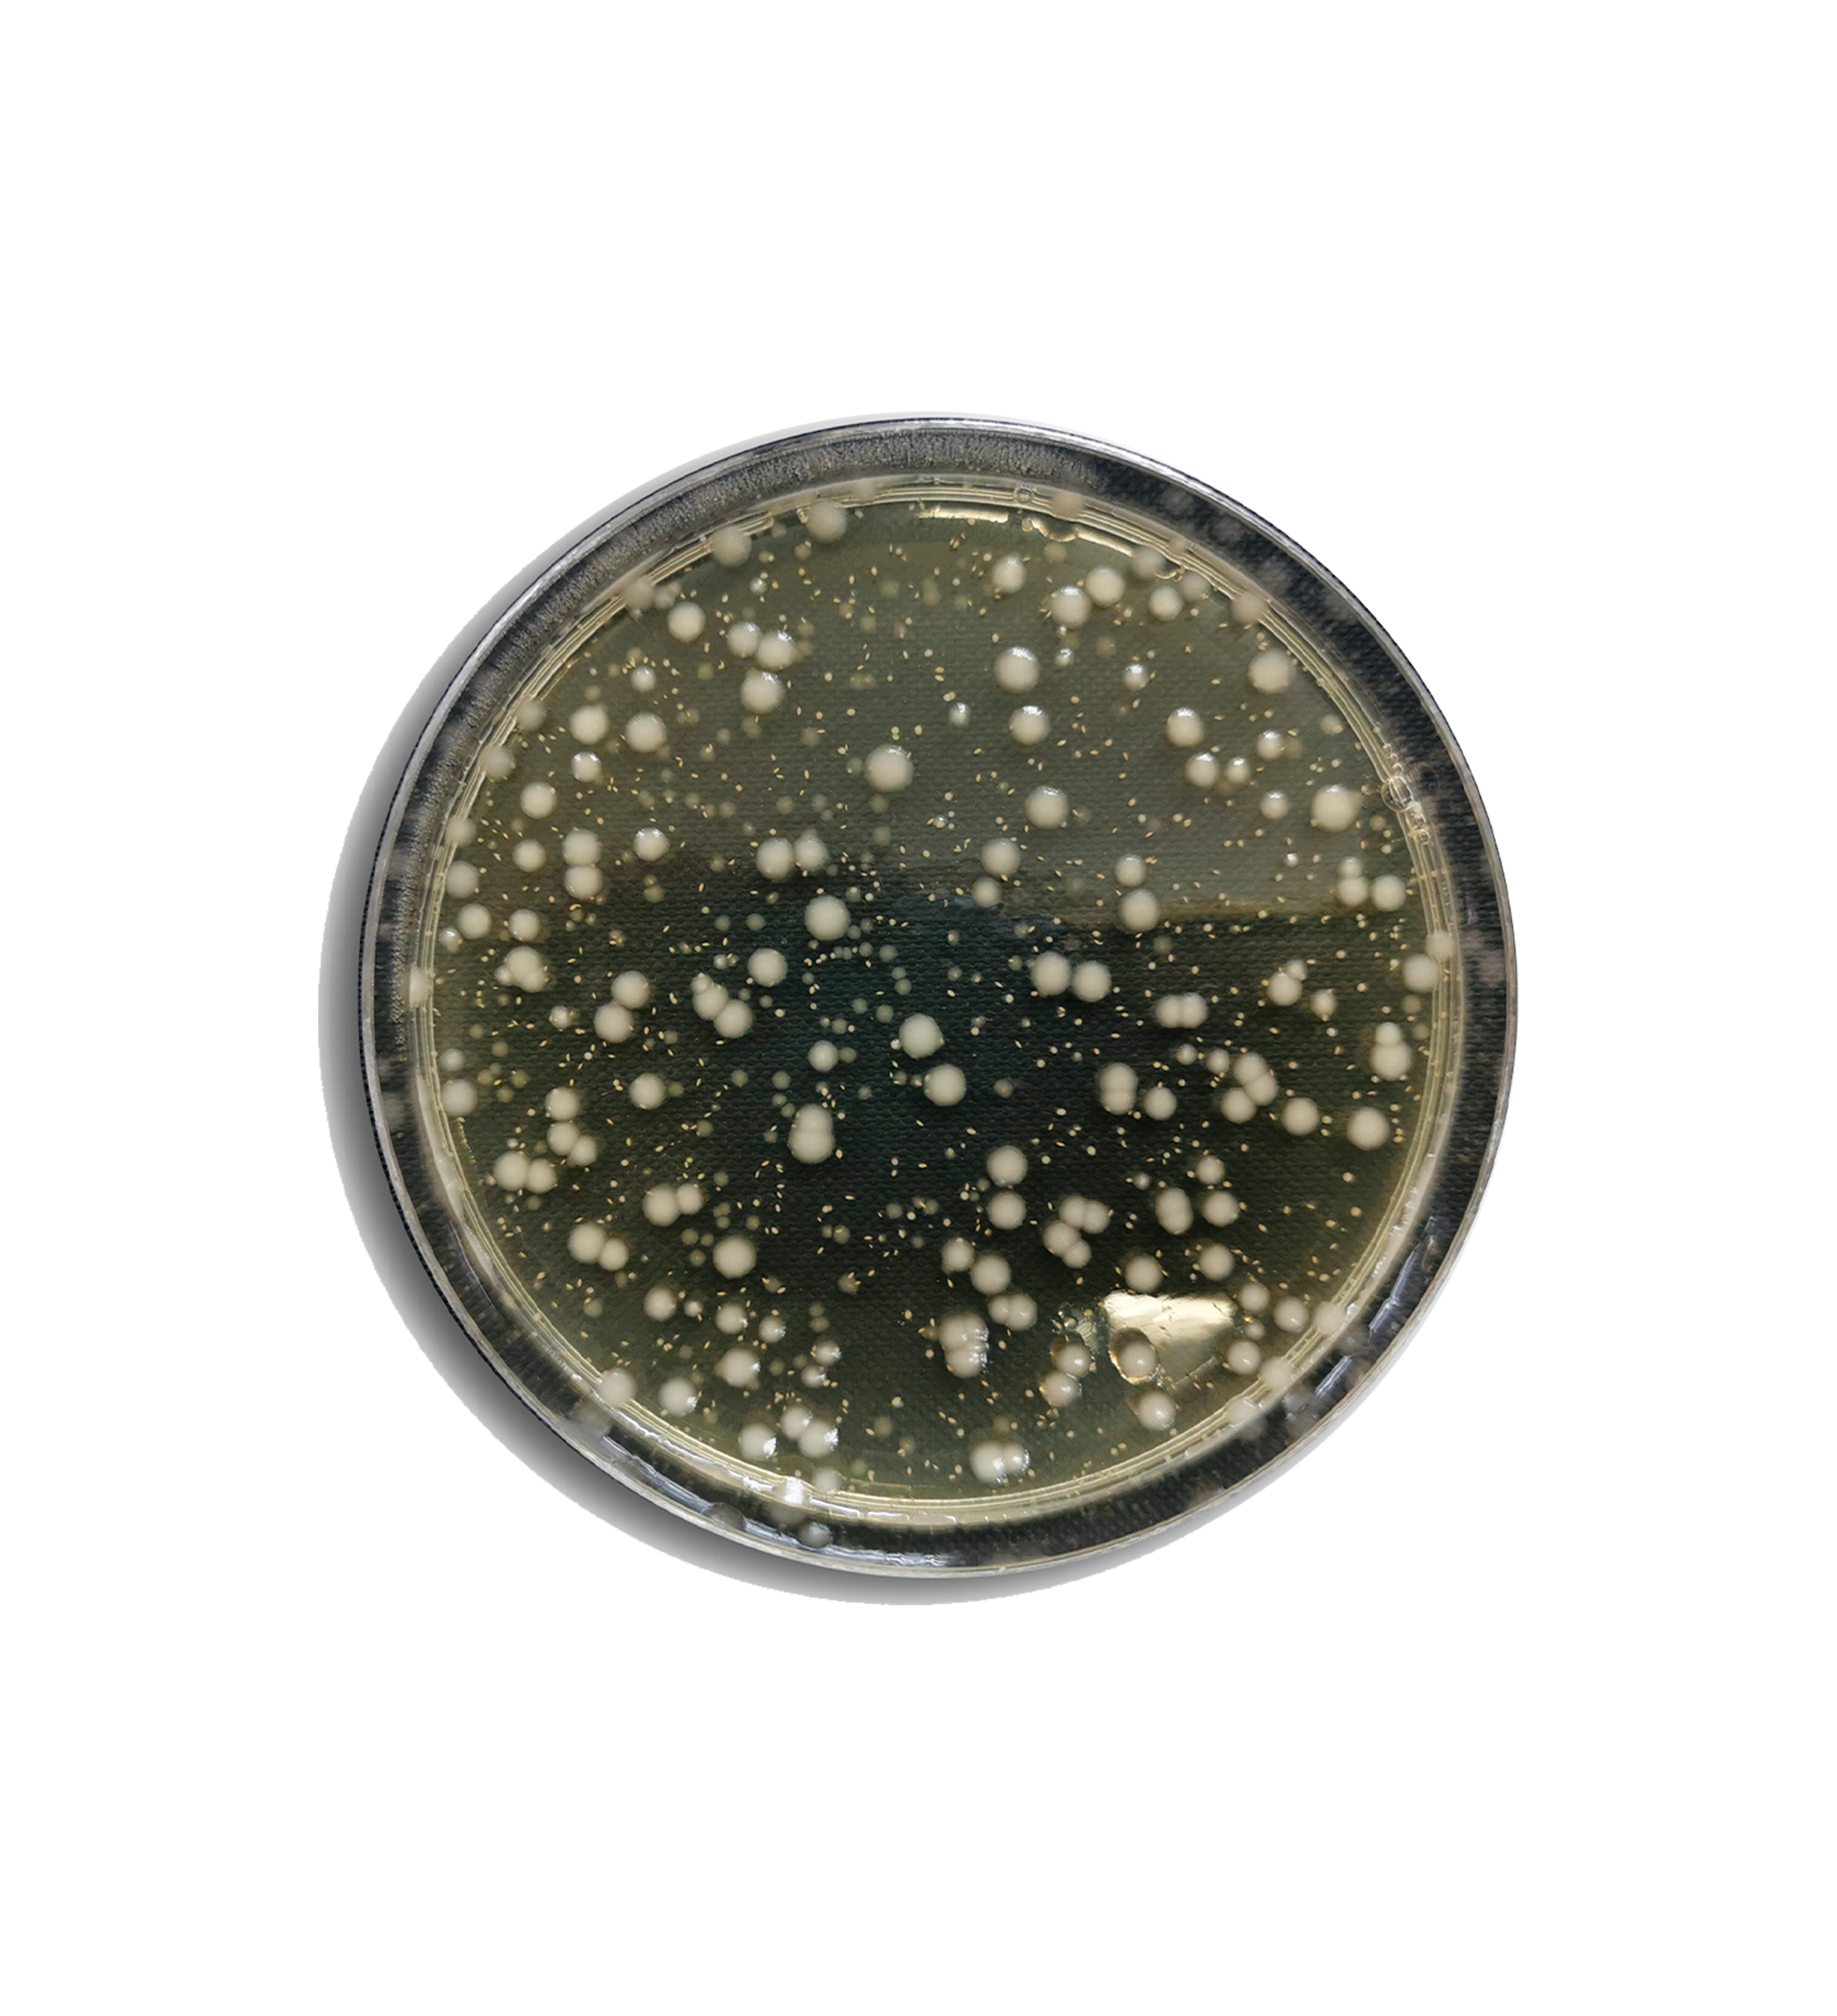

Night Herbal
- Regular price
- $99.00
- Sale price
- $99.00
- Regular price
Positive effects on stress relief and sleep improvement
Learn More About This Product
Get helpful updates and detailed information about this product, including features, usage tips, and availability alerts.
Learn More About This Product
Get helpful updates and detailed information about this product, including features, usage tips, and availability alerts.
Shipping & Returns
Find all the essential information about our shipping timelines and return policies to shop with confidence.














PRIMARY RIMARY INGREDIENT FUNCTION
Primary Ingredients and Mechanism of Action for Each Product

Iron Amino Acid - PLUS
Iron + Biotin Dual-Action Synergy
High-Concentration Keratin Restructures Hair Texture


Hair Scalp Nutritional
Strengthen Roots & Prevent Hair Loss Reverse Aging & Enhance Blackness Purify & Balance Lift & Restructure


Night Herbal · PLUS
Premium South African Bitter Melon blended with Premium St. John's Wort— Dual relief for body and mind!


AMPK Metabolic Activator
Patent-certified core ingredients selectively activate brown fat to enhance thermogenesis and fat-burning efficiency, reducing stubborn abdominal fat.

Men’s Hair Vitamins
Revitalize the scalp / Nourish hair follicles / Strengthen hair roots / Block DHT


The chelated structure of ferrous glycine prevents direct contact between iron ions and gastrointestinal mucosa, and its absorption does not depend on gastric acidity. This significantly reduces irritation for individuals with gastrointestinal sensitivity, such as pregnant women, children, and the elderly.


Mildly Irritating

High Absorption Rate

No Interference
Cyclical
Scientifically Formulated Cycle Therapy
Here can be a commonly asked question about your product or service.
Here can be a brief but clear response to the question, giving customers a quick answer without unnecessary details.
1-2 Weeks-Symptom Relief Stage
4-8 Weeks-Iron Reserve Recovery Stage
2-3 Months or More-Indicator Stabilization Stage
Find your Ritual
What are You Looking for?
Account
- Choosing a selection results in a full page refresh.

























